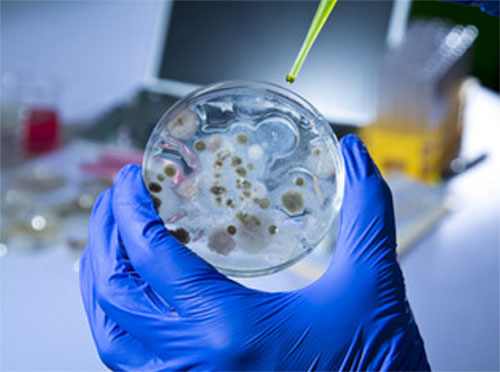
Чашка Петри с ростом микроорганизмов

Доброго времени суток, уважаемые читатели. Сегодня мы поговорим о таком явлении, как стоматит у детей во рту. В этой статье мы рассмотрим классификацию данного заболевания, выясним основные причины и клиническую картину. Вам станет известно, как лечить данный недуг и как соблюдать меры предосторожности.
Разновидности заболевания
Основываясь на том, как болезнь протекает, различают лёгкую степень, среднюю и тяжёлую.
Исходя из различной этиологии, рассматривают шесть видов стоматита. Классификация основывается на типе возбудителя. Так стоматиты бывают:
- Вирусный. В 81 проценте случаев заболевание вызывает вирус герпеса. Именно поэтому данный тип стоматита еще называют герпетическим. Чаще всего он встречается у малышей в возрасте от года до трех лет. После инфицирования полностью избавиться от возбудителя не получается, он так и остаётся в организме, но никак себя не проявляет до момента резкого снижения иммунитета. Тогда стоматит может принять и хронический характер. Заболевание характеризуется:
- снижением или отсутствием аппетита;
- раздражительностью;
- гипертермией свыше 38 градусов;
- головной болью;
- общей слабостью;
- высыпаниями на слизистой ротовой полости в виде пузырьков, заполненных жидкостью.
- Бактериальный. Чаще всего возникает на фоне системной болезни (ангины, отита, пневмонии и даже кариеса), выступает в качестве вторичной инфекцией. Возбудители данного типа стоматита — стафилококки и стрептококки. Встречается у детей разных возрастов при несоблюдении правил личной гигиены, когда малыши тянут все в рот, при употреблении немытых продуктов. Характерными симптомами являются:
- гипертермия до 38, 5 градусов;
- корочки на губах;
- образование гнойного содержимого в язвочках.
- Грибковый (кандидозный). Чаще всего встречаются у детей первого года жизни. Возбудителем является грибок дрожжеподобного типа Candida. Активно размножаться начинает при ослабленном иммунитете или после приема антибиотиков. Характерной симптоматикой является:
- незначительное повышение температурного показателя;
- плаксивость, капризность;
- ухудшения аппетита;
- возникновения налета белого цвета на слизистой ротовой полости, имеющего резкий запах.
- Аллергический. Развивается в качестве иммунного ответа организма на воздействие аллергена. К признакам данного типа относятся:
- болезненные ощущения;
- зуд;
- отек слизистой.
- Травматический. Возникает вследствие химического или механического поражение слизистой ротовой полости: травмирование острым краем какого-то объекта, прикусывание щеки с внутренней стороны, ожоги. К основным признакам относятся:
- возникновение язвочки или ссадины;
- практически во всех случаях подсоединяется вторичная инфекция, образуется гной.
- Афтозный. Развивается на фоне аутоиммунного заболевания, не без участия инфекционного процесса. Отличительной особенностью является появление язвочек, имеющих круглые края, так называемых афт, отсюда и произошло название этого типа.
Врачи отмечают, что стоматит у детей проявляется различными симптомами, включая покраснение и отек слизистой оболочки рта, появление язвочек, а также болезненность при приеме пищи. Часто дети жалуются на зуд и жжение, что может приводить к отказу от еды и питья. Важно своевременно обратиться к врачу для диагностики, так как стоматит может быть вызван вирусами, бактериями или грибками. Лечение обычно включает антисептические растворы для полоскания, противовоспалительные препараты и, в некоторых случаях, антибиотики. Специалисты подчеркивают, что поддержание гигиены полости рта и укрепление иммунной системы играют ключевую роль в профилактике рецидивов. Родителям рекомендуется следить за состоянием ребенка и при необходимости обращаться за медицинской помощью.

Причины заболевания
Определяются несовершенством иммунитета, анатомическими особенностями слизистой ротовой полости ребёнка и не соблюдением основных правил гигиены. Маленькие дети имеют еще неокрепшую иммунную систему, поэтому больше подвержены влиянию болезнетворных микроорганизмов. Если у малыша тонкая и нежная слизистая, она с легкостью травмируется, образуются ранки, в которые достаточно быстро проникают патогенные агенты. Например, когда ребёнок при прорезывании зубов тянет в рот разные предметы, чтобы почесать десна, то же касается и употребления немытых фруктов. Кроме того, слюна взрослого человека имеет антисептические свойства, то есть взрослый организм успешно борется с проникновением болезнетворных микроорганизмов, собственно почему стоматиту больше подвержены дети.
Болезнь развивается от внедрения и активного размножения бактерий, вирусов, грибков, под воздействием аллергенов, травмирующих факторов, присутствии аутоиммунного заболевания. Стоматит также может возникать из-за гиповитаминоза, на фоне сахарного диабета, недостатка железа или вследствие приема антибиотиков, при гормональном изменении в организме в период полового созревания.
Также имеются факторы, которые повышают вероятность возникновения заболевания:
- несоблюдение гигиены;
- состояние постоянного стресса;
- некачественное, несбалансированное питание;
- сильное переохлаждение или перегрев;
- наследственная предрасположенность.
Симптомы
Признаки заболевания зависят от типа возбудителя, состояния иммунитета малыша в момент болезни и от присутствия провоцирующих факторов.
Вы можете увидеть, как различается стоматит у детей (симптомы), фото разных типов заболевания:
При рассмотрении проявлений можно заметить:
- При вирусном типе пузырьки, образовавшиеся на слизистой, достаточно быстро лопаются, на их месте появляются ранки, которые могут сливаться между собой и при этом возникает сильная болезненность. На слизистой появляется желтый налет. Воспаление распространяется на лицо ребенка. Если речь идет о герпетическом типе, то на месте пузырьков будут появляться язвочки, которые быстро заживают. Что характерно, если возбудителем стал вирус герпеса, то пузырьки появляются не только в ротовой полости, но и на губах, и опускаются в горло.
- Грибковый тип характеризуется появлением сухости во рту; потом на языке, деснах и губах развиваются точки белого цвета, которые со временем сливаются между собой и покрываются налетом. При попытке снять эту пленочку, возникнет ранка, которая будет кровоточить. Будет характерным наличие кислого запаха изо рта и жжение.
- При бактериальном типе слизистая оболочка ротовой полости приобретает багрово красный оттенок, появляются язвочки, на губах развиваются корочки желтого цвета. Также характерно обильное слюноотделение и присутствие гнилого запаха со рта малыша.
- При афтозном типе появляются болезненные места, язвочки с круглыми краями, которые покрыты налетом белого цвета. Что характерно, температурный показатель длительное время удерживается на завышенной отметке.
- Аллергический тип характеризуется сильным отеком, наличием зуда и болезненностью.
- При травматическом типе появляются ранки вследствие повреждения механическим или химическим путем, также возможно отягощение инфекционным процессом.
Если рассматривать общие симптомы стоматита у детей, то можно выделить наличие таких признаков:
- Гипертермия. Может быть как незначительной, так и повышаться до 40 градусов в зависимости от типа стоматита.
- Общая слабость, вялость, капризность и плаксивость.
- Тошнота.
- Заложенность носа.
- Отечность и гиперемия слизистой оболочки ротовой полости.
- Появление пузырьков, эрозий, покрытие слизистой налетом серого, белого или желтоватого цвета.
- Наличие кислого или гнилостного запаха со рта.
- Ухудшение или отсутствие аппетита.
- Повышенное слюноотделение.
- Увеличение шейных лимфоузлов.
Если вы обнаружили, что у малыша появились какие-то симптомы из этого списка, необходимо обратиться к врачу для постановки точного диагноза и определение типа возбудителя. Только после этого назначенное лечение будет целесообразным.
Стоматит у детей — это распространенная проблема, о которой родители часто делятся своим опытом. Многие отмечают, что первые симптомы, такие как покраснение и отечность слизистой оболочки рта, могут проявляться неожиданно. Дети могут жаловаться на боль при еде или питье, что вызывает беспокойство у родителей. Важно помнить, что стоматит может быть вызван различными факторами, включая вирусные инфекции, аллергии или недостаток витаминов.
Лечение стоматита обычно включает в себя использование антисептических растворов для полоскания рта и специальных гелей для облегчения боли. Родители советуют не забывать о важности гигиены полости рта и избегать острых и кислых продуктов, которые могут усугубить состояние. Также многие рекомендуют консультацию с педиатром или стоматологом для назначения подходящей терапии. В целом, своевременное обращение за медицинской помощью и соблюдение рекомендаций специалистов помогают быстро справиться с этой неприятной проблемой.

Диагностика
Для постановки правильного диагноза и точного определения типа стоматита ребенку предстоит пройти ряд исследований:
- Первоначально врачом будет проведён осмотр и сбор жалоб пациента. После того, как врач получит полную клиническую картину, он сможет сделать выводы о предположительном диагнозе.
- Чтоб убедиться в своей правоте доктор отправит вас на лабораторные исследования. В первую очередь у ребенка возьмут соскоб со слизистой оболочки. Это необходимо для определения типа возбудителя.
- Дополнительно будут назначены клинически исследование крови, мочи, также возможен биохимический анализ крови.
- В случае бактериального стоматита, могут провести исследование на определение рода возбудителя, это необходимо для подборки чувствительности к определенному антибиотику.
Лечение
Если вы задаетесь вопросом, как вылечить стоматит у ребенка, то необходимо учитывать, что это напрямую будет зависеть от того, кто стал возбудителем данного типа заболевания.
Курс лечения включает в себя соблюдение трех правил, независимо от вида патологии:
- Коррекция питания. Важно соблюдать диету, исключить кислую, холодную, горячую соленую пищу. Употреблять только жидкие или полужидкие блюда.
- Общее укрепление иммунной системы. В период болезни нужно принимать витамины, микроэлементы для повышения опорных свойств организма.
- Терапия местного действия. Включает в себя борьбу с конкретным типом возбудителя и снятием характерных симптомов.
А теперь давайте более детально рассмотрим способ лечения в зависимости от типа стоматита:
- Вирусная форма включает в себя:
- применение противовирусных препаратов, например, мазь с ацикловиром. Часто используются Виролекс, Оксолиновая мазь, Герпевир;
- для укрепления иммунной системы могут назначаться Интерферон или Иммунал;
- для уменьшения воспалительного процесса, снижения температуры, снятия отечности и болезненных ощущений применяют гель Холисал. Также помогает в борьбе с вирусами, уничтожает источник заболевания.
- Бактериальный стоматит лечат:
- антисептическими спреями, например, Гексорал или Орасепт;
- деткам старше шести лет назначают сосательные леденцы;
- раствор для ополаскивания полости рта, например, Мирамистин;
- гели с метронидазолом;
- возможно назначение антибиотиков.
- Для лечения кандидозного типа используют такие назначения:
- применение противогрибковой мази, например Клотримазол;
- полоскание ротовой полости содовым раствором, что позволяет создать щелочную среду, которая уничтожает грибки. Такой вариант лечения назначают малышам первого года жизни, потому как им еще запрещены многие лекарства. Для приготовления данного раствора используют чайную ложку соды и стакан теплой воды. Обрабатывать ротовую полость рекомендуется до шести раз за сутки;
- применение крема Кандид противогрибкового действия;
- витаминотерапия;
- использование препаратов, поддерживающих иммунитет;
- в случае высокой температуры, прием жаропонижающих медикаментов;
- при таком виде заболевания важно соблюдать диету, исключающую все сладости.
- Афтозный тип включает в себя такие методы лечения:
- При лечении травматического типа используют препараты для заживления ранок, также антисептические средства. Может применяться гель Солкосерил, назначаться полоскание Хлоргексидином или раствором соды.
- При лечении аллергического типа заболевания будут назначены антигистаминные препараты. Обязательным является исключение аллергена, вызвавшего заболевания, из окружения ребенка. Также необходимо провести терапию всех сопутствующих симптомов, которые развились на фоне ответной реакции организма на раздражитель.
Также допустимо лечение стоматита в домашних условиях.
Особенности ухода
- При возникновении стоматита важное значение имеет соблюдение диеты. При наличии ранок, малышу будет больно есть привычную пищу, поэтому вам необходимо кормить ребёнка жидкими или полужидкими блюдами, не употреблять сырые фрукты и овощи, особенно кислые. Карапузам старше шестимесячного возраста необходимо давать йогурт, но только не сладкий или простоквашу. Сладкое вообще необходимо исключить, так как оно влияет на активный рост и размножение микроорганизмов.
- Позаботьтесь об отдельной посуде, полотенце для больного малыша.
- Занимайтесь регулярным проветриванием и проведением влажных уборок, как можно чаще.
- Не перекармливайте карапуза, но и не оставляйте его голодным.
- В период болезни не рекомендуется купать ребенка, достаточно аккуратно его протереть.
Народные способы лечения
Некоторые родители следуют советам старшего поколения и решают процедуры лечения свести к использованию народной медицины. Однако, этого делать не стоит. Все применения медикаментов, даже если они натуральные, необходимо согласовывать с лечащим врачом. Только он сможет определить тип заболевания, выяснить чувствительность микроорганизмов к конкретному лечению и рассчитать правильную дозировку.
Для обработки язвочек могут использоваться такие препараты:
- Зеленка является хорошим антисептиком. Ей можно обрабатывать внешние зоны высыпаний. Данный препарат активно борется с микроорганизмами, при этом не наносит вред коже ребенка, не сушит ее. Целесообразно использование зеленку при грибковом, бактериальном или вирусном стоматите. Однако, не рекомендуется применять при наличии кровоточащих ранок.
- Квасцы жженые помогают снять воспалительный процесс, останавливают сочащуюся кровь, хорошо снимают ощущение зуда. Действие этого средства носит обеззараживающий и заживляющий характер.
- Пищевая сода также обладает противовоспалительным эффектом, относится к антацидным средствам, активно борется с наличием язвочек на слизистой ротовой полости.
Меры профилактики

Теперь вы знаете, что собой представляет такое заболевания, как стоматит. Вы выяснили, какие формы в зависимости от этиологии, различают у такой болезни. Важно понимать необходимость своевременного диагностирования патологии. Прочитав статью, вы узнали, чем лечить стоматит у детей во рту. Но также не маловажное значение имеют профилактические мероприятия, ведь намного проще предупредить болезнь, чем лечить, не говоря уже об ощущениях ребёнка в этот период. Приучайте своего карапуза к соблюдению правил личной гигиены с самого раннего детства. Желаю здоровья вам и вашим малышам!
Вопрос-ответ
Как понять, что у ребенка стоматит?
Общими признаками для любой формы стоматита у детей являются повышенная температура, изъязвление слизистых ротовой полости и увеличение лимфоузлов.
Что хорошо помогает от стоматита во рту детям?
Детям от 3 лет можно использовать препараты «Гексорал», «Максиколд Лор», «Тантум верде», «Мирамистин», мазь от стоматита «Алпизарин». С 6 лет можно использовать гель «Метрогил Дента», раствор от стоматита «Стоматидин». Лечить детей нужно обязательно под контролем стоматолога или педиатра.
Как выглядит начальная стадия стоматита?
Симптомы вирусного стоматита на начальной стадии его развития легко спутать с проявлениями обычной простуды. У больного поднимается температура тела, появляется головная боль. Постепенно слизистая полости рта сильно отекает и краснеет, больному становится трудно жевать и глотать.
Советы
СОВЕТ №1
Обратите внимание на первые симптомы стоматита, такие как покраснение и отек слизистой оболочки рта, а также появление язвочек. Чем раньше вы заметите эти признаки, тем быстрее сможете обратиться к врачу для назначения правильного лечения.
СОВЕТ №2
Поддерживайте гигиену полости рта вашего ребенка. Регулярная чистка зубов мягкой щеткой и использование антисептических растворов помогут предотвратить развитие стоматита и ускорить заживление уже имеющихся язв.
СОВЕТ №3
Следите за рационом питания ребенка. Избегайте острых, кислых и жестких продуктов, которые могут раздражать слизистую оболочку рта. Предпочитайте мягкую и питательную пищу, чтобы не усугублять состояние.
СОВЕТ №4
Обязательно проконсультируйтесь с педиатром или стоматологом, если симптомы стоматита не проходят в течение нескольких дней или ухудшаются. Врач сможет назначить необходимые препараты и дать рекомендации по уходу за полостью рта.